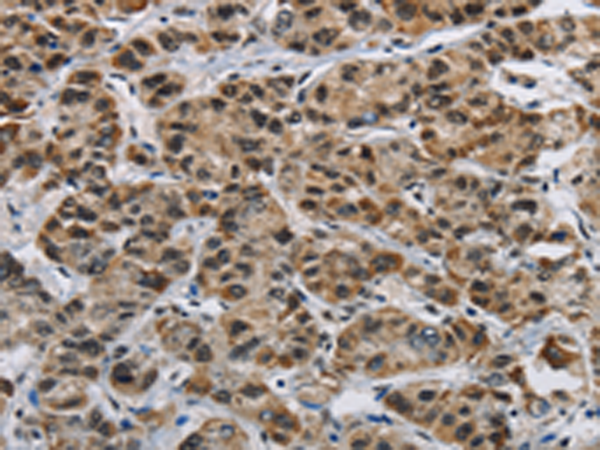
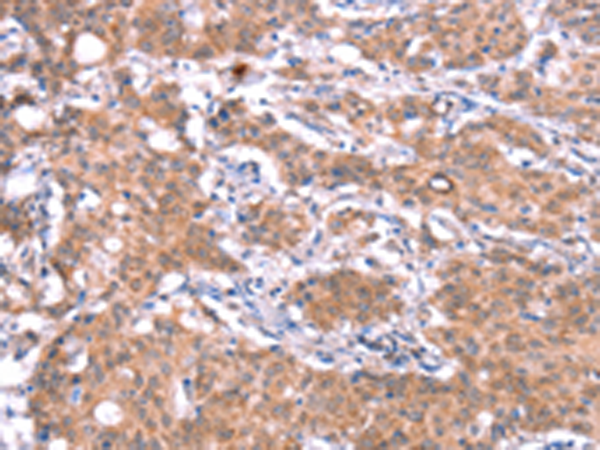

-
分类: 科研抗体货号: P11786别名: PSORT; GIDRP86; GIDRP88; C10orf28应用: IHC反应种属: Human, Mouse
-
分类: 科研抗体货号: P11784别名: GH; GHN; GH-N; hGH-N; IGHD1B应用: WB,IHC反应种属: Human
-
分类: 科研抗体货号: P11803别名:应用: WB,IHC反应种属: Human, Mouse
-
分类: 科研抗体货号: P11783别名: Geph应用: IHC反应种属: Human, Mouse, Rat
-
分类: 科研抗体货号: P11819别名: HNRPL; hnRNP-L; P/OKcl.14应用: WB,IHC反应种属: Human, Mouse
-
分类: 科研抗体货号: P11802别名: PAR2; RFT1; RBFVD; RFVT1; hRFT1; GPCR42; GPR172B应用: IHC反应种属: Human
-
分类: 科研抗体货号: P11782别名: GCP2; GCP-2; h103p; hGCP2; SPBC97; Spc97p; hSpc97; Grip103应用: IHC反应种属: Human, Mouse
-
分类: 科研抗体货号: P11818别名:应用: WB,IHC反应种属: Human, Mouse
-
分类: 科研抗体货号: P11800别名: GDH2; GPDM; mGPDH应用: WB,IHC反应种属: Human, Mouse, Rat
-
分类: 科研抗体货号: P11781别名: GAS11应用: IHC反应种属: Human, Mouse, Rat

鄂公网安备42018502007531号
鄂公网安备42018502007531号

